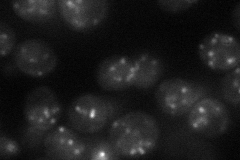
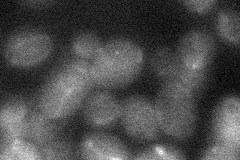
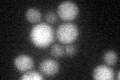
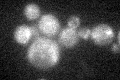

View description
Component of UDP-GlcNAc transferase required for the second step of dolichyl-linked oligosaccharide synthesis; anchors the catalytic subunit Alg13p to the ER membrane; similar to bacterial and human glycosyltransferases
Localization:
Intensity:
Fold change:
Significance:
-
C’ GFP library in SD

cytosol21.84 -
N' NOP1pr-GFP in SD
punctate31.3502 -
N' TEF2pr-mCherry in SD

ER37.3092 -
N' NATIVEpr-GFP in SD

punctate21.636 -
N' TEF2pr-VC and Cyto-VN in SD
below threshold22.8584 -
C’ GFP library in SD+DTT
cytosol16.210.74No -
C’ GFP library in SD+H2O2
cytosol20.930.95No -
C’ GFP library in Starvation Media

cytosol18.680.85No -
C’ GFP library on the background of Pup2-DaMP

cytosol -
C’ GFP library on the background of CCT mutant

cytosol18.76860.859044No
